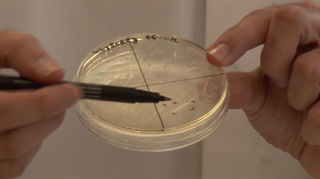
Martian Death Rays

Resources
We’ve worked with lots of organisations, scientists and teachers to develop educational resources and activities.
Thanks to funding and the people we have worked with, many of these are free to use in school, youth groups and at home.
Browse, download and use the activities and resources on the grid below. Using the inspiring context of space, they cover tricky topics and curriculum subjects for biology, chemistry, physics and maths.
Use the filter to narrow down resources by topic!